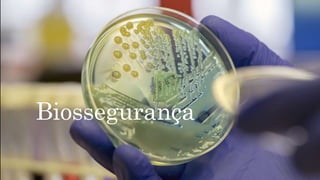
Biossegurança

O documento discute os conceitos e práticas de biosseguridade em suínos e aves. A biosseguridade envolve a implementação de normas e procedimentos para prevenir a entrada e disseminação de agentes patogênicos e garantir a saúde dos animais e segurança dos produtos derivados. O texto descreve os oito pontos críticos da biosseguridade e medidas para cada um, como desinfecção de pessoas e veículos, controle de pragas e monitoramento.